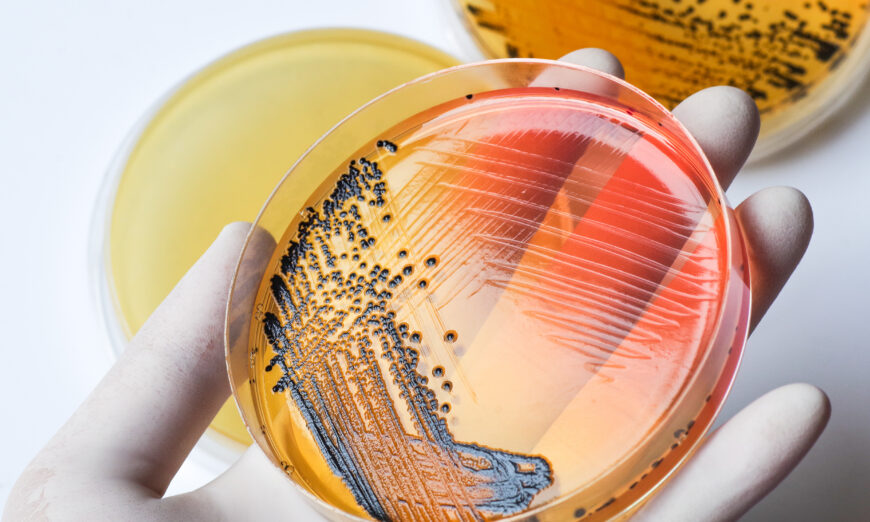

Trí tuệ nhân tạo xấu xa bại hoại chẳng ở đâu xa mà ở ngay trước mắt chúng ta

Viễn cảnh người nhân bản trong phim viễn tưởng Blade Runner rốt cuộc không còn xa nữa
Hồi tháng 11/2022, sự ra mắt của chương trình trò chuyện trực tuyến trí tuệ nhân tạo (AI) có tên ChatGPT đã gây chấn động thế giới. Chương trình này “thông minh” đến mức nó đưa ra những phản ứng giống con người một cách đáng sợ và dường như có rất ít sai sót so với các phiên bản trước. Mọi người không chỉ xem công cụ này như một người bầu bạn mà còn bắt đầu sử dụng công nghệ AI này cho nhiều nhiệm vụ khác nhau, chẳng hạn như hoàn thành bài tập về nhà, tạo ra những bức ảnh ngoài sức tưởng tượng, làm thơ, v.v.
Sử dụng ChatGPT giống như truy cập vào bộ não của một siêu máy điện toán, khiến công nghệ này trở nên hấp dẫn và thú vị nhưng cũng hơi đáng sợ và mang tính đe dọa. Năm 2014, ông Elon Musk đã cảnh báo rằng với AI, “chúng ta đang triệu hồi quỷ dữ,” nhưng mối đe dọa này chỉ có thể trở thành hiện thực khi AI như ChatGPT có thể tạo ra câu trả lời cho những câu hỏi không giống với cách mà con người sẽ trả lời. Công nghệ này mạnh mẽ đến mức hiện đang có nhiều người lo ngại rằng bối cảnh của nhiều ngành công nghiệp sẽ bị thay đổi do sự tiến triển công nghệ này, bao gồm cả học thuật và chăm sóc sức khỏe.
Những công việc thường đòi hỏi sự tiếp xúc của con người, chẳng hạn như những công việc trong lĩnh vực báo chí và ngành dịch vụ, đang phải đối mặt với sự thay thế và tự động hóa. Từ lâu chúng ta đã nghĩ rằng nghệ thuật ngôn ngữ là đỉnh cao trí tuệ của con người, nhưng AI đang bắt đầu thể hiện sức mạnh trong lĩnh vực đó. Công nghệ này đang thách thức sự độc đáo của chúng ta và xâm nhập vào cuộc sống của chúng ta.
AI hiện đã rất tân tiến và có khả năng
ChatGPT về căn bản có thể trò chuyện về bất cứ điều gì quý vị muốn. Từ việc phân tích mã cho quý vị đến viết các bài luận và bài thơ đầy đủ, chương trình trực tuyến miễn phí này tự mô tả là một chương trình máy điện toán được thiết kế để “hiểu và phản hồi các đầu vào ngôn ngữ tự nhiên,” chẳng hạn như các cuộc hội thoại bằng văn bản.
ChatGPT là viết tắt của Chat Generative Pre-training Transformer. Chương trình này dựa trên một tập hợp các công nghệ được phát triển và sử dụng trong các chương trình trò chuyện thân thiện với người dùng. AI là một công cụ cần được dạy cách suy nghĩ và hồi đáp bằng cách sử dụng công nghệ có chức năng như các mạng lưới thần kinh. Quá trình này liên quan đến việc cung cấp cho AI hàng núi thông tin trước khi nó có thể xử lý, thích nghi, học hỏi, sáng tạo, và trở nên thông minh.
ChatGPT sử dụng phiên bản GPT mới nhất và có khả năng tạo một lượng lớn văn bản giống con người dựa trên đầu vào tối thiểu. Ứng dụng này đã xử lý một lượng dữ liệu lớn ngoài sức tưởng tượng cho phép nó tìm hiểu những gì cần hồi đáp cho người dùng khi được hỏi một câu hỏi. Ví dụ: nếu quý vị yêu cầu ChatGPT sáng tác một bài thơ, nó sẽ xuất ra nội dung như sau:
“Beneath the starry sky so bright,
With gentle breeze and silver light,
I stand and gaze into the night,
And let my thoughts take flight.
The moon and stars above me shine,
Guiding me through the dark divine,
Reminding me of love and time,
And all the beauty that is mine.
The world is vast, yet small and grand,
A mystery waiting to be scanned,
With secrets hidden in the sand,
And stories waiting to be canned.
So let me stand beneath the stars,
And let my soul and spirit soar,
For in this beauty, free from bars,
I find my heart forevermore.”
Diễn nghĩa:
“Dưới bầu trời đầy sao sáng ngời,
Với làn gió nhẹ và ánh bạc,
Tôi đứng và nhìn vào màn đêm,
Và hãy để suy nghĩ của tôi cất cánh.
Mặt trăng và các ngôi sao trên tôi tỏa sáng,
Hướng dẫn tôi qua bóng tối thiêng liêng,
Nhắc nhở tôi về tình yêu và thời gian,
Và tất cả vẻ đẹp đó là của tôi.
Thế giới rộng lớn, nhưng nhỏ bé và vĩ đại,
Một bí ẩn đang chờ được khai mở,
Với những bí mật ẩn giấu trong cát,
Và những câu chuyện đang chờ đóng hộp.
Vì vậy, hãy để tôi đứng dưới những vì sao,
Và hãy để linh hồn và tinh thần của tôi bay lên,
Vì trong vẻ đẹp này, không hạn chế,
Tôi tìm thấy trái tim của tôi mãi mãi.”
Tạm dịch:
“Dưới bầu trời đêm
ánh sao lấp lánh,
gió nhè nhẹ thổi
bàng bạc ánh kim
Tôi dừng chân bước
nhìn ngắm màn đêm,
thả hồn theo gió
thả trí theo mây
Trăng sao rực rỡ
trên bầu trời kia,
dìu tôi qua những
góc tối tâm hồn
Tình yêu, thời gian
nhắc cho tôi nhớ,
rằng vẻ đẹp đó
là của chính tôi
Thiên thể mênh mông
con người nhỏ bé,
bí ẩn đằng kia
chờ tôi khai mở
Những điều huyền áo
giấu trong cát vàng,
những câu chuyện hay
chờ tôi viết tiếp
Tôi chỉ muốn đứng
dưới các vì sao,
để hồn bay cao
để tâm thanh thản
Vì vẻ đẹp này
mới là tự tại,
tôi đã tìm được
tâm thức của mình.
Bài thơ này nghe cũng khá ấn tượng phải vậy không? Với khối lượng dữ liệu lớn được cung cấp cho ChatGPT, chương trình này có thể xử lý các bài thơ của chúng ta, phân tích, và tạo ra một bài thơ mới chỉ trong vài giây. Và có thể mỗi lần đều cho ra kết quả khác nhau, ngay cả khi quý vị đưa ra cùng một lệnh cho nó.
ChatGPT cũng có thể làm điều tương tự với các bài tiểu luận, cả các đoạn mã code, và còn hơn thế nữa. Chương trình này có thể trò chuyện bình thường với quý vị và biết cách điều chỉnh biệt ngữ của mình, thậm chí có thể giải thích điện toán lượng tử theo cách mà học sinh lớp bảy có thể hiểu được.
Rất dễ hiểu tại sao chương trình này ngay lập tức thu hút rất nhiều người, vì dường như nó có thể giải quyết nhiều vấn đề và cung cấp một con đường tắt quan trọng để hoàn thành các nhiệm vụ. Trò chuyện thì miễn phí còn hiệu quả thì tuyệt vời; vậy vấn đề có thể xảy ra với loại công nghệ này là gì, ngoại trừ việc trở thành cơn ác mộng cho các giáo viên?
ChatGPT không thể chịu trách nhiệm cho tác phẩm của mình
Gần đây, các nhà khoa học đã thử nghiệm các hạn chế của ChatGPT và hướng dẫn chương trình này viết ra các phần của các bài báo nghiên cứu mà sau đó đã được đăng trên các tạp chí khoa học danh tiếng như Nature. Sau khi thông tin về việc AI có thể viết bài nghiên cứu được lan truyền, vấn đề này đã trở thành tâm điểm của một cuộc tranh luận hiện vẫn sôi nổi trong cộng đồng.
Các lập luận ủng hộ AI xem công nghệ như ChatGPT là bước kế tiếp trong sự tiến bộ của con người. Chương trình này thậm chí sẽ làm cho khoa học hiệu quả hơn, giảm thiểu sức lao động của con người, và làm cho cuộc sống trở nên dễ dàng hơn.
Mặt trái của lập luận này là không có cách nào để buộc trí tuệ nhân tạo chịu trách nhiệm cho tác phẩm mà nó tạo ra. Nếu chương trình đưa ra kết luận sai lệch hoặc thuật toán của nó chưa đủ thuần thục, vậy làm sao để chương trình này có thể chịu trách nhiệm về điều đó?
Vấn đề về trách nhiệm giải trình không chỉ là khi mọi thứ đi sai hướng. Ông Holden Thorp, tổng biên tập của nhóm tạp chí Khoa học cho biết, việc sử dụng văn bản do AI tạo ra mà không có trích dẫn phù hợp “có thể được xem là đạo văn.” Vì lý do đó, một số bài báo đã được xuất bản với việc liệt kê ChatGPT là một trong số các tác giả, trong khi các nhà xuất bản đang đẩy nhanh việc thúc đẩy quy định.
Trên thực tế, sau khi các bài báo được xuất bản trên tạp chí Nature với ChatGPT là đồng tác giả, tổng biên tập của Nature và Science đã kết luận rằng “ChatGPT không đáp ứng tiêu chuẩn về quyền tác giả” bởi vì một chức danh như vậy cũng đi kèm với trách nhiệm giải trình và trách nhiệm pháp lý, vốn là điều không khả thi đối với AI.
Tuy nhiên, vấn đề cốt lõi đằng sau tranh cãi về quyền tác giả là các biên tập viên tạp chí giờ đây không còn biết được bao nhiêu phần trong một bài báo hoặc những nội dung nào là sản phẩm của ChatGPT. Các thí nghiệm khoa học có thể vẫn cần các nghiên cứu do con người thực hiện. Nhưng các tác giả của các bài báo đánh giá cho rằng ChatGPT có thể đã làm như vậy vì nó đóng một vai trò quan trọng trong quá trình viết.
Một số nhà nghiên cứu y sinh đã sử dụng ChatGPT để tiến hành nghiên cứu phát triển dược phẩm và đã có thể xác định các thành phần hóa học tiềm năng của dược phẩm đã bị bỏ sót trong quá khứ. Với sự trợ giúp của AI, một thời đại mới với những tiến bộ bùng nổ trong lĩnh vực y sinh chắc chắn sẽ được mở ra.
Tuy nhiên, làm thế nào để các nhà nghiên cứu biết được khi nào dữ liệu AI trở nên sai lệch? Liệu có ai dám thách thức các thuật toán đằng sau dữ liệu này không? Đây không phải là những nghi vấn duy nhất mà chúng ta phải đối mặt ngày nay, bởi vì AI dường như cũng đang đảm nhận việc chăm sóc sức khỏe, hoạt động như một người máy hoặc thông qua một ứng dụng.
Trí tuệ nhân tạo không thể thay thế nhân viên y tế
Một số phòng khám đã và đang tìm cách sử dụng ChatGPT để tiến hành tư vấn cho bệnh nhân. Các phòng khám sức khỏe tâm thần thậm chí còn đạt được kết quả làm việc tốt hơn khi họ sử dụng ChatGPT để đảm nhiệm việc tư vấn cho bệnh nhân, trong đó nhiều bệnh nhân thậm chí còn không nhận ra rằng họ đang nói chuyện với một con robot.
Trong thời gian tới, AI có thể trở thành trợ lý y tá hoặc trợ lý bác sĩ, giúp quý vị phục hồi sau tai nạn, hoặc thực hiện các vết rạch quan trọng trong ca phẫu thuật sắp tới. Tương lai của ngành y tế có thể thay đổi nhanh chóng, vì mọi người thậm chí có thể không phải đến phòng khám bác sĩ nhờ vào sự kết hợp giữa AI và y tế từ xa. Tất cả những gì quý vị cần làm là mở một ứng dụng trên điện thoại của mình và trò chuyện với một hộp trò chuyện tự động (chatbot), nói với phần mềm này về các triệu chứng của quý vị, và nó sẽ kê đơn cho quý vị. Tuy nhiên, mức độ tin cậy được hình thành trong quá trình trò chuyện và tiếp xúc trực tiếp chính là một yếu tố mà mô hình AI này không thể có được.
Các robot AI sử dụng GPT cũng có thể được áp dụng để điều trị cho những bệnh nhân có nguy cơ cao, chẳng hạn như những người bị rối loạn tâm thần hoặc đang điều trị trong trại cai nghiện, bằng cách thay thế bác sĩ khi theo dõi bệnh nhân và thực hiện điều trị, tiến hành kiểm tra, đánh giá rủi ro, và hành động nếu cần. Tuy nhiên, câu hỏi về trách nhiệm giải trình tương tự cũng xuất hiện khi chúng ta áp dụng AI vào lĩnh vực y khoa.
Ở đây, câu hỏi về trách nhiệm giải trình là đáng lưu tâm hơn, bởi vì ai sẽ chịu trách nhiệm khi bệnh nhân gặp các biến chứng do dùng sai thuốc hoặc sai liều lượng? Quý vị không thể đổ lỗi cho bác sĩ vì ông ấy chỉ làm theo AI. Quý vị không thể đổ lỗi cho AI vì đó là một chương trình ứng dụng. Vậy rốt cuộc, ai sẽ là người phải chịu trách nhiệm?
Để mọi người cảm thấy an toàn về vấn đề AI, các quy tắc trách nhiệm pháp lý nghiêm ngặt cần được áp dụng để hạn chế quyền tự do mà những thứ này có được. Tuy nhiên, nếu các chương trình này muốn cải thiện, chúng cần có nhiều quyền tự do hơn để hoạt động và học hỏi. Mặc dù đây có vẻ là một điểm đáng chú ý, nhưng vấn đề cốt lõi là liệu con người có nên để AI và robot chăm sóc cho chúng ta hay không.
Với khả năng của AI ngày càng được nâng cao theo cấp số nhân, vì sao các trường y khoa thậm chí còn đào tạo sinh viên của họ và đào tạo để làm gì? Trong tương lai, nếu AI mất điện hoặc gặp trục trặc, liệu các bác sĩ được cấp phép có còn biết cách điều trị cho bệnh nhân mà không cần sự trợ giúp của AI hay không? Chúng ta sẽ trở nên phụ thuộc vào AI đến mức độ nào?
Nhân loại đang tiến tới một thời khắc quan trọng
AI có rất nhiều tiềm năng và chắc chắn sẽ trở thành một phần trong tương lai của chúng ta. Tuy nhiên, việc cho phép AI đóng một vai trò quan trọng hơn trong y học và chăm sóc sức khỏe sẽ giúp ứng dụng này có thêm sức mạnh để tác động đến hiểu biết của chúng ta về sức khỏe và tinh thần. Điều này thậm chí có thể cho phép AI thay đổi cơ thể chúng ta.
Nếu AI trở nên phổ biến, liệu ứng dụng này có khiến con người trở nên lười suy nghĩ hơn và khiến chúng ta giảm sút về mọi mặt không? Theo thời gian, trẻ em có thể chỉ nói chuyện với máy tính bảng chatbot của mình thay vì nói chuyện với cha mẹ, mọi người có thể quên cách thức làm giảm bớt các triệu chứng của những bệnh thông thường như cảm lạnh, và các bài tập căn bản như viết một bài luận có thể trở thành dĩ vãng. Điều này chắc chắn sẽ làm suy yếu khả năng của con người và ảnh hưởng đến sự phát triển của chúng ta. Khi công nghệ trở nên tân tiến đến mức chúng ta có thể điều khiển robot bằng tâm trí của mình, liệu một ngày nào đó chúng ta có thể biến thành những người ngoài hành tinh với tay chân cao lêu nghêu và chiếc đầu bự không?
Khi AI bắt đầu bắt chước suy nghĩ của con người và nói ngôn ngữ giống con người, chúng ta bắt đầu thấy thực tế của bộ não con người: Chúng thực chất là những cỗ máy xử lý thông tin. Khi các máy tính thu thập đủ khối lượng dữ liệu, chúng có thể sử dụng một thuật toán tinh vi để tạo ra phản ứng và suy nghĩ giống như con người. Càng nhiều người sử dụng nó, ChatGPT AI sẽ càng học hỏi được nhiều hơn để trở nên giống con người hơn, cuối cùng nó sẽ hiểu biết nhiều hơn cả loài người.
Vậy điều gì khiến con người chúng ta trở nên độc nhất?
Chúng ta đã chứng kiến các siêu máy điện toán đánh bại các nhà vô địch cờ vua và cờ vây là con người.
Giờ đây, AI đã xuất hiện trong các lĩnh vực mà con người thực sự tự hào — các lĩnh vực xoay quanh sự sáng tạo, cảm xúc, tương tác giữa con người với nhau, biểu cảm nghệ thuật, v.v.
Đây là thời điểm quan trọng mà con người cần suy nghĩ sâu sắc hơn xem trí huệ của chúng ta đến từ đâu. Có phải nguồn cảm hứng của chúng ta chỉ đơn giản được sinh ra từ sự tích lũy vô số dữ liệu? Trí tuệ nhân tạo và máy điện toán lấy dữ liệu từ đầu vào của con người hoặc thông qua việc dò tìm độ sâu của biển dữ liệu. Liệu chính chúng ta có được những ý tưởng “nguyên bản” của mình theo cách này không? Tại sao mọi người có được nguồn cảm hứng và ý tưởng sáng tạo dường như không liên quan gì đến kinh nghiệm và kiến thức trước đây của họ?
Mối đe dọa của AI và siêu máy điện toán không chỉ là lấy đi cơ hội việc làm của con người. Mà nó còn đi xa hơn thế, đó là làm giảm khả năng tư duy của con người. Mối đe dọa căn bản của công nghệ AI không được kiểm soát là nó cắt đứt sợi dây kết nối của nhân loại với Sáng Thế Chủ của chúng ta. Thông qua những tiến bộ về công nghệ, con người đang tạo dựng nên các vị Thần ‘kỹ thuật số’ để nhân loại tôn thờ và sùng bái. Sử dụng AI hoặc robot để cải thiện cuộc sống có thể là mặt tích cực của viên thuốc này, nhưng sử dụng AI để thay thế cho tư duy của con người lại là mặt tối.
Vấn đề cấp bách ở đây là làm thế nào để bảo vệ tinh thần của chúng ta. Làm thế nào để chúng ta duy trì kết nối của chúng ta với Thần? Con người không phải chỉ bằng xương bằng thịt, giống như một cỗ máy chỉ đơn thuần được lắp ráp từ các linh kiện cơ khí.
Sự phát triển của các công nghệ AI như ChatGPT là bước ngoặt cho một vấn đề lâu nay mà chúng ta vẫn đang đối mặt — sự (mất) kết nối với Thần và ý nghĩa thực sự của cuộc sống con người khi chúng ta thay thế kết nối đó. Chúng ta phải đối mặt với một sự lựa chọn: Chúng ta có tiếp tục rơi vào cái hố công nghệ không đáy này không, hay chúng ta nên quay trở lại con đường truyền thống nơi con người duy trì sự kết nối của mình với các vị Thần?
Và có lẽ bài viết “Vì sao có nhân loại” của ông Lý Hồng Chí sẽ cung cấp cho chúng ta một số điều đáng để suy ngẫm.
Nhóm biên dịch tin tức Anh ngữ Epoch Times Tiếng Việt
Quý vị tham khảo bản gốc từ The Epoch Times